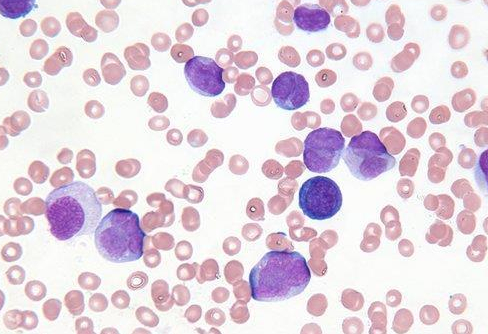

【资讯导读】慢性粒细胞白血病(CML)是造血干细胞的克隆性骨髓增生性肿瘤。它的标志性特征是Ph染色体,即T(9;22)(q34;Q11)。致病性是基于9q34上的c-abl易位到22q11上的bcr基因的3’端,形成bcr-abl融
慢性粒细胞白血病(CML)是造血干细胞的克隆性骨髓增生性肿瘤。它的标志性特征是Ph染色体,即T(9;22)(q34;Q11)。致病性是基于9q34上的c-abl易位到22q11上的bcr基因的3’端,形成bcr-abl融合基因。融合基因编码的bcr-abl融合蛋白具有高酪氨酸激酶活性。因此,酪氨酸激酶抑制剂(TKI)可特异性抑制bcr-abl的表达,阻断细胞信号转导,抑制bcr-abl阳性细胞的增殖,诱导细胞生长停滞和凋亡,但对体内所有酪氨酸激酶也有抑制作用,从而引起人体各系统的不良反应,主要包括血液学反应和非血液学反应。
伊马替尼是第一代TKI药物。它可以竞争性地靶向和抑制bcr-abl酪氨酸激酶,并使CML患者获得高的血液学和细胞遗传学应答率。目前,伊马替尼已成为慢性粒细胞白血病患者的首选一线治疗药物。
伊马替尼常见的血液不良反应主要是中性粒细胞减少症、血小板减少症和贫血。非血液学不良反应主要包括消化系统异常如恶心、呕吐和腹泻,皮肤和皮下组织异常如皮疹和红皮病,以及液体潴留如水肿。
根据临床和国内外资料,绝大多数不良反应为轻度至中度,可通过支持对症治疗来缓解。大多数不良反应发生在治疗的早期,绝大多数是自我限制的。晚期患者的不良反应多于慢性期患者。严重不良反应可减轻或暂停治疗,缓解后应逐步恢复用药;不合理的药物减少或治疗中断将导致疾病的快速发展。
伊马替尼药品详细信息请进入:https://www.inmedf.com/zhongliu/bxb/201951.html